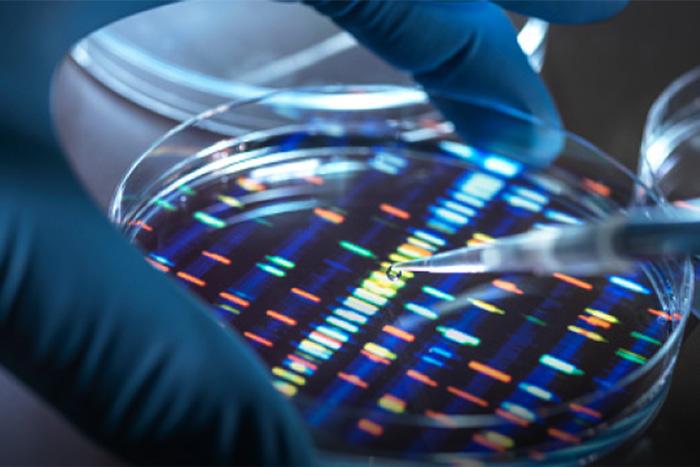
DSPM: Healthcare Data Security Amid Rising Breaches DSPM: Healthcare Data Security Amid Rising Breaches

Blog Zscaler
Recevez les dernières mises à jour du blog de Zscaler dans votre boîte de réception
Automating Data Governance: Strengthening Security with Zscaler DSPM and MPIP Integration
In the modern enterprise, tracking business-critical data has moved beyond a simple administrative task—it has become a "superhuman" challenge. As data is generated, modified, and moved across sprawling multi-cloud environments and SaaS applications, maintaining visibility and control is increasingly difficult for even the most well-resourced security teams.
To manage this complexity, many organizations rely on data labeling. By classifying data at the point of creation, organizations can help end-users understand the sensitivity of the information they handle. Furthermore, labeling is no longer just a "best practice"; it is a core requirement for many global compliance frameworks that mandate the identification of critical business assets.
The Role of Microsoft Purview Information Protection
Most organizations center their labeling strategy around user-generated data residing in cloud or on-premises file shares. To do this, they leverage Microsoft Purview Information Protection (MPIP)—formerly known as Azure Information Protection (AIP) —to map sensitive data, control access, and trigger security settings like encryption.
Because MPIP labels are stored as persistent metadata within the files themselves, the protection "travels" with the data. This allows security teams to use these labels as anchors for Data Loss Prevention (DLP) and Cloud Access Security Broker (CASB) policies, ensuring consistent enforcement regardless of where the file resides.
Bridging the Gap: Zscaler DSPM and MPIP Integration
While MPIP provides the framework for labeling, Zscaler Data Security Posture Management (DSPM) provides the global engine for discovery, classification and validation.
Zscaler DSPM continuously scans your data universe ranging from cloud, SaaS applications to on premise data centres—to identify and catalog files. With this integration, Zscaler DSPM now detects the MPIP labels associated with every file.
Zscaler DSPM doesn't just read the label; it scans the content of the file using prebuilt and custom classifiers. By comparing the actual data against the existing label, Zscaler DSPM helps enable organizations to:
- Identify and correct mislabeled sensitive files.
- Automatically apply MPIP labels to unlabeled sensitive data.
- Validate labeling accuracy across the entire data estate.
This automated validation reduces the manual "toil" on IT and security operations teams while significantly hardening the organization’s overall security posture.
Key Benefits of the Zscaler DSPM MPIP Integration
1. Comprehensive Visibility and Historical Remediation
Traditional labeling often misses legacy data or "shadow data" created before strict policies were in place. Zscaler DSPM identifies sensitive data missing MPIP labels and allows you to apply classifications to both historical archives and newly created or modified data.
2. Cross-Cloud Labeling Enforcement
One of the primary challenges of MPIP is extending its logic beyond the Microsoft ecosystem. Zscaler DSPM bridges this gap by detecting and applying MPIP labels to files stored in non-Microsoft environments, such as Amazon S3 buckets. This helps to ensure a unified classification standard across your entire multi-cloud strategy.
3. Optimized Business Context
Security labels are often siloed within IT departments and underutilized by security teams. Zscaler DSPM breaks these silos by correlating MPIP labels with other risk signals and data profiles. By seeing the actual content inside a labeled file, security teams can demystify labeling schemes and ensure they align with specific business objectives.
4. Unified Policy Management and "Label-Driven" Security
To prevent policy drift, Zscaler allows you to use sensitivity labels as automated policy triggers. This ensures that a label of "Highly Confidential" automatically invokes encryption or restricts exfiltration in high-risk scenarios. Making MPIP labels the "source of truth" for Zscaler security policies helps create a seamless enforcement experience for both admins and end-users.
5. Simplified Regulatory Compliance
For organizations navigating the complexities of GDPR, HIPAA, or PCI-DSS, this integration provides a robust technical control. It streamlines the labeling of business-critical data, providing a clear, automated audit trail ready for internal auditors and external regulators alike.
Conclusion
The integration of Zscaler DSPM and MPIP represents a shift from passive monitoring to active, automated enforcement. By ensuring your data is correctly classified and protected everywhere it travels, you can finally close the "enforcement gap" and reduce the risk of high-impact data breaches.
Ready to see Zscaler DSPM in action?
While the MPIP integration is a powerful component of our platform, Zscaler’s DSPM solution offers even deeper capabilities for risk reduction and data discovery. A picture is worth a thousand words—schedule a session with one of our experts to see how we can secure your data estate.
Cet article a-t-il été utile ?
Clause de non-responsabilité : Cet article de blog a été créé par Zscaler à des fins d’information uniquement et est fourni « en l’état » sans aucune garantie d’exactitude, d’exhaustivité ou de fiabilité. Zscaler n’assume aucune responsabilité pour toute erreur ou omission ou pour toute action prise sur la base des informations fournies. Tous les sites Web ou ressources de tiers liés à cet article de blog sont fournis pour des raisons de commodité uniquement, et Zscaler n’est pas responsable de leur contenu ni de leurs pratiques. Tout le contenu peut être modifié sans préavis. En accédant à ce blog, vous acceptez ces conditions et reconnaissez qu’il est de votre responsabilité de vérifier et d’utiliser les informations en fonction de vos besoins.
Recevez les dernières mises à jour du blog de Zscaler dans votre boîte de réception
En envoyant le formulaire, vous acceptez notre politique de confidentialité.